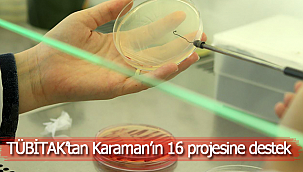

Kentteki ONGUN muamması
Editör: Karaman Ajans
25 Mart 2024 - 16:26
Temel tüketime konu olan üretimlerin piyasadaki fiyatlarının yükselmesini önlemek, tüketicinin daha uygun fiyatla alış veriş yapmasını sağlamak amacıyla yıllar evvel kurulmuştu Ongun A. Ş.. Halkın dönemsel ihtiyaçlarının karşılanması adına odun, kömür, un ve şeker gibi malzemeleri satardı. Bir dönem, içinde ne ararsan bulabildiğin marketi bile vardı. Günümüzdeki tanzim satış uygulamasının, yıllar evvelki versiyonuydu Karaman için. Piyasa istikrarı sağlandığı dönemlerde kabuğuna çekilen ancak, ürünlere erişimin zor ve pahalı olduğu durumlarda görev üstlenen, tedarik sağlayan bir çalışma yöntemi vardı. Bu yönü dolayısıyla bazı dönemler sönük, bazı dönemler ise çok aktif bir şekilde Karamanlının hayatında hep yer aldı. Fakat hiçbir parti veya belediye başkanı döneminde bu şekilde şaibelerle yer almamıştı.
Ongun’un, Savaş Kalaycı dönemi
Geçmişteki bu misyonunun aksine Kalaycı döneminde Ongun, adına ‘Pestelma’ denilen lokum ile ‘Saya’ denilen ayakkabı tabanı işine girdi. Bu işler için de tabiî ki yüzlerce kişi işe alındı. Net rakamı asla paylaşmıyorlar ancak, kamuoyuna yansıyan bilgilere göre 2 bine yakın hemşerimiz Ongun’da çalışıyor veya çalışıyor gibi gösteriliyor! Şirkette bahse konu üretimlerin gerçekten yapılıp yapılmadığı konusunda kimsenin bir fikri yok. Fakat ilimizin Organize Sanayi Bölgesi’nde 2 bin kişinin çalıştığı herhangi bir fabrikaya gitsek, dışarıdan bile bakarak içeride üretim yapıldığını anlayabiliriz. Zira yüzlerce kişinin elinden çıkan ürünler, günlük tırlarca yük demektir ve o fabrikaya her gün yanaşan tırlar yükünü alır gider. Ongun’da böyle bir duruma şahit olan da yok, peki bu kadar personel ne yapıyor?
Kalaycı, personeli sahiplenmiyor
Karaman’daki birçok siyasinin yanı sıra vatandaşların da eleştirilerinin odağında olan Ongun, yöneltilen hiçbir sorunun cevap bulamadığı bir kurum haline geldi. Bir zamanlar kentin can damarı olan şirket, şimdi gölgelerin karanlığında adeta boğuluyor. Siyaset sahnesindeki figürler; bazı personelin mafya benzeri işlerde kullanıldığını, bazılarının maaş alırken işe gitmediklerini ve bazılarının da görevlerini ihmallerle yürüttüklerini iddia ediyorlar. Üstelik internet ortamına düşen ses kayıtları da bu eleştirileri doğrular nitelikte olunca, şehir yeni bir kavram kazandı, ‘’Onguncular’’..
Yeni açılan parkta bir kişinin öldürülmesi, Belediyedeki makamda silahlı kavga ve gazetecinin evinin kurşunlanması olayları, bu ‘’Onguncular’’ kavramının kullanıldığı olayların sadece bir kaçı. Personel içerisindeki eli silahlı bir grubun yaptıkları, işini doğru düzgün yapan personelin de aynı şaibeden nasiplenmesinin nedeni oluyor. Bunca karanlık işe ve hepimizin emaneti olan şirkete dair şaibeler arşa çıkarken, Savaş Kalaycı’dan ses çıkmıyor. Hiçbir siyasiye cevap vermediği gibi, personelini de sahiplenmiyor. Bu durum, Kalaycı’nın seçim sonrası Ongun çalışanları ile yolunu ayıracağı intibası oluşturuyor. Kulislerde konuşulan iddialara göre, zaten yüzlerce personel seçim yatırımı niyetiyle oy alabilmek için işe alınmış. Bu iddiaların sesi çok duyulmaya başladığından Kalaycı’nın önümüzdeki günlerde göstermelik birkaç temel atma işine gireceği ve ‘’Fabrika açacağım, bu personeli de orada çalıştıracağım’’ diyerek hayali bir proje başlatacağı konuşuluyor. Vatandaşlar ise, bu işin de tıpkı drift alanı gibi milyonlarca lira harcanıp yarım yamalak kalacağı görüşünde hemfikir.
Bu açıdan bakıldığında, Kalaycı’nın seçim sonrası yüzlerce personeli kapının önüne koyacağına kesin gözüyle bakılıyor. Ailesinin rızkı için Ongun’da işe başlayan ve verilen her bir görevi özverili bir şekilde yürüten, işinde gücünde olan personel, Başkanından üzerlerine yapışan şaibeleri arındırmasını ve kendilerini sahiplenmesini bekliyor! Bağırarak olmasa da fısıldayarak soruyor, ‘’Ongun, şehre değer katması gereken bir yer mi, yoksa kirli işlerini çözdürdüğün adres mi?’’
Ongun’un, Savaş Kalaycı dönemi
Geçmişteki bu misyonunun aksine Kalaycı döneminde Ongun, adına ‘Pestelma’ denilen lokum ile ‘Saya’ denilen ayakkabı tabanı işine girdi. Bu işler için de tabiî ki yüzlerce kişi işe alındı. Net rakamı asla paylaşmıyorlar ancak, kamuoyuna yansıyan bilgilere göre 2 bine yakın hemşerimiz Ongun’da çalışıyor veya çalışıyor gibi gösteriliyor! Şirkette bahse konu üretimlerin gerçekten yapılıp yapılmadığı konusunda kimsenin bir fikri yok. Fakat ilimizin Organize Sanayi Bölgesi’nde 2 bin kişinin çalıştığı herhangi bir fabrikaya gitsek, dışarıdan bile bakarak içeride üretim yapıldığını anlayabiliriz. Zira yüzlerce kişinin elinden çıkan ürünler, günlük tırlarca yük demektir ve o fabrikaya her gün yanaşan tırlar yükünü alır gider. Ongun’da böyle bir duruma şahit olan da yok, peki bu kadar personel ne yapıyor?
Kalaycı, personeli sahiplenmiyor
Karaman’daki birçok siyasinin yanı sıra vatandaşların da eleştirilerinin odağında olan Ongun, yöneltilen hiçbir sorunun cevap bulamadığı bir kurum haline geldi. Bir zamanlar kentin can damarı olan şirket, şimdi gölgelerin karanlığında adeta boğuluyor. Siyaset sahnesindeki figürler; bazı personelin mafya benzeri işlerde kullanıldığını, bazılarının maaş alırken işe gitmediklerini ve bazılarının da görevlerini ihmallerle yürüttüklerini iddia ediyorlar. Üstelik internet ortamına düşen ses kayıtları da bu eleştirileri doğrular nitelikte olunca, şehir yeni bir kavram kazandı, ‘’Onguncular’’..
Yeni açılan parkta bir kişinin öldürülmesi, Belediyedeki makamda silahlı kavga ve gazetecinin evinin kurşunlanması olayları, bu ‘’Onguncular’’ kavramının kullanıldığı olayların sadece bir kaçı. Personel içerisindeki eli silahlı bir grubun yaptıkları, işini doğru düzgün yapan personelin de aynı şaibeden nasiplenmesinin nedeni oluyor. Bunca karanlık işe ve hepimizin emaneti olan şirkete dair şaibeler arşa çıkarken, Savaş Kalaycı’dan ses çıkmıyor. Hiçbir siyasiye cevap vermediği gibi, personelini de sahiplenmiyor. Bu durum, Kalaycı’nın seçim sonrası Ongun çalışanları ile yolunu ayıracağı intibası oluşturuyor. Kulislerde konuşulan iddialara göre, zaten yüzlerce personel seçim yatırımı niyetiyle oy alabilmek için işe alınmış. Bu iddiaların sesi çok duyulmaya başladığından Kalaycı’nın önümüzdeki günlerde göstermelik birkaç temel atma işine gireceği ve ‘’Fabrika açacağım, bu personeli de orada çalıştıracağım’’ diyerek hayali bir proje başlatacağı konuşuluyor. Vatandaşlar ise, bu işin de tıpkı drift alanı gibi milyonlarca lira harcanıp yarım yamalak kalacağı görüşünde hemfikir.
Bu açıdan bakıldığında, Kalaycı’nın seçim sonrası yüzlerce personeli kapının önüne koyacağına kesin gözüyle bakılıyor. Ailesinin rızkı için Ongun’da işe başlayan ve verilen her bir görevi özverili bir şekilde yürüten, işinde gücünde olan personel, Başkanından üzerlerine yapışan şaibeleri arındırmasını ve kendilerini sahiplenmesini bekliyor! Bağırarak olmasa da fısıldayarak soruyor, ‘’Ongun, şehre değer katması gereken bir yer mi, yoksa kirli işlerini çözdürdüğün adres mi?’’

YORUMLAR